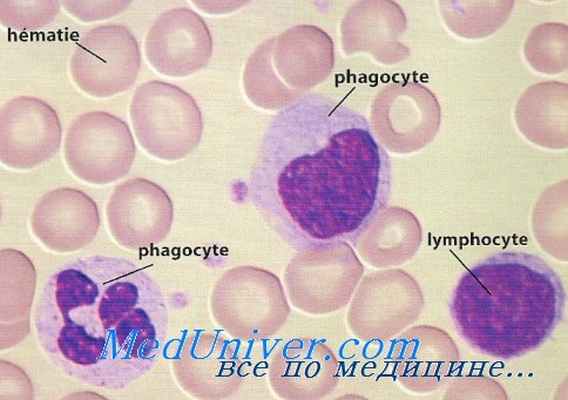
мононуклеарные лейкоциты

Пролиферация мононуклеарных лейкоцитов. Влияние иммуномодуляторов на лейкоциты
Добавил пользователь Владимир З. Обновлено: 27.01.2026
Следующая большая группа – синтетические препараты.
Полиоксидоний – иммуномодулятор отечественного производства. Основной механизм иммуномодулирующего действия – прямое воздействие на моноцитарно-макрофагальные клетки, нейтрофилы и естественные киллеры (NK-клетки), вызывая повышение их функциональной активности при исходно сниженных показателях. Механизм активации реализуется на уровне плазматической мембраны и связан с повышением ее проницаемости для ионов кальция. Повышает устойчивость мембран клеток к цитотоксическому действию лекарственных препаратов и химических веществ, что является основой детоксикационной активности препарата. Усиливает кооперацию Т- и В-лимфоцитов, стимулирует пролиферацию Т-лимфоцитов. Выброс большого количества цитокинов макрофагами активирует всю иммунную систему. Стимулирует антителообразование [39]. Полиоксидоний обладает способностью связывать на своей поверхности различные токсические вещества, в том числе бактерии, усиливая их выведение из организма [40]. Полиоксидоний удаляет из организма кислотные радикалы, снижая тем самым их повреждающее действие [41,49].
Используется при хронических рецидивирующих воспалительных заболеваниях любой этиологии, аллергических заболеваниях [42]. Если Полиоксидоний вводить через день по 6-12 мг 10 раз, то мембраностабилизирующая и детоксикационная активность позволяет снизить гепато- и нефротоксичность во время химиотерапии. Препарат способствует быстрому восстановлению онкологических больных после операций и существенному улучшению их самочувствия [134].
Для профилактики иммунодепрессивного влияния опухоли, коррекции нарушений препарат можно принимать 1-2 раза в неделю 2-3 месяца по 6 мг или в форме суппозиториев 6-12 мг 2 раза в неделю от 2-3 месяцев до года.
Иммуномодулятор с системным цитопротективным действием Глутоксим относится к классу тиопоэтинов.
Оказывает модулирующее действие на внутриклеточный обмен тиола, играющего важную роль в регуляции метаболических процессов. Новый уровень окислительно-восстановительных процессов и динамики фосфорилирования белков систем, передающих сигналы, и факторов транскрипции иммунокомпетентных клеток определяет иммуномодулирующий и цитопротективный эффект препарата. В нормальных клетках Глутоксим стимулирует процессы пролиферации и дифференцировки, в трансформиро-ванных индуцирует апоптоз. Обладает высокой тропностью к клеткам центральных органов иммунологической защиты и лимфоидной ткани. Усиливает костно-мозговое кроветворение, активизирует фагоцитоз, восстанавливает функциональную активность макрофагов, инициирует систему цитокинов, эритропоэтина.
Предназначен для профилактики и лечения вторичных иммунодефицитов, как гепатопротектор – при вирусных гепатитах, потенцирует эффект антибактериальной терапии, улучшает переносимость химиотерапии [43]. Профилактическая доза 10 мг ежедневно 10 дней.
Галавит – следующий представитель синтетических иммуномодуляторов, производное аминофталгидрозида.
Нормализует функциональное состояние макрофагов, ингибирует их на 6-8 часов при гиперактивности, уменьшает этим избыточный синтез ФНО и ИЛ-1, снижая степень выраженности воспалительной реакции [142]. Стимулирует микробицидную функцию нейтрофильных гранулоцитов при ее дефиците, регулирует пролиферативную активность Т-лимфоцитов, стимулирует активность NK-клеток при ее недостаточности, усиливает фагоцитоз и повышает неспецифическую резистентность организма к инфекциям [140,142]. Ингибирует образование перекисных соединений, определяющих развитие диарейного и токсического синдрома, поэтому эффективен при острых кишечных инфекциях, сопровождающихся диареей и интоксикацией, воспалительных заболеваниях ЖКТ [147].
Применяется при инфекционных заболеваниях, гнойно-септических процессах, иммунодефицитах различной этиологии [146]. Препарат ускоряет репарацию раневых поверхностей, язв и эрозий кожи и слизистых [140]. У больных диссеминированным раком молочной железы не только улучшил иммунный статус, но и позитивно влиял на качество жизни [141]. В онкологии для иммунокоррекции Галавит назначают по 100 мг через день 5 раз, далее один раз в 3 дня до 20 введений или ректально в суппозиториях.
Тимоген – низкомолекулярный синтетический пептид, оказывающий регулирующее влияние на реакции клеточного и гуморального иммунитета, а также на неспецифическую резистентность. Синтез тимогена явился последовательным событием, вытекающим из изучения биологических экстрактов тимуса, когда выяснилось, что за биологическое действие отвечает не вся молекула экстрагированного вещества, а только часть ее. Активность большой молекулы, состоящей из нескольких десятков или сотен аминокислотных остатков, попытались воспроизвести короткими пептидными последовательностями из 2-4 аминокислот, которые обозначили как тимомиметики. Первым тимометиком стал тимоген, внедренный в медицинскую практику в 1987 г. Тимоген не является фрагментом гормона тимуса, дипептид глутамил-триптофана (Glu-Trp), на основе которого он изготовлен, входит также в состав молекул цитокинов, сывороточных иммуноглобулинов.
Иммуномодулирующие свойства тимогена реализуются путем передачи содержащегося в Glu-Trp сигнала через систему вторичных посредников. В результате этого изменяются структура и функциональные свойства ядерного хроматина, что активизирует процессы транскрипции, повышается подвижность клеток крови. Тимоген усиливает дифференцировку лимфоидных клеток за счет экспессии на Т-лимфоцитах дифференцировочных антигенов. Проявляет сродство к мембранным рецепторам тимоцитов и вызывает экспрессию на их мембранах CD- и DR-молекул. Препарат нормализует соотношение Т-хелперов и Т-супрессоров при иммунодефицитных состояниях, а также оказывает воздействие на колониестимулирующую активность костного мозга. Мирошниченко И.В. с соавторами в 1997 г выяснили, что доза тимогена, необходимая для усиления процесса дифференцировки лимфоидных клеток, в 10-100 раз меньше, чем природных препаратов вилочковой железы. В организме препарат распадается на триптофан и глутаминовую кислоту.
Используется при комплексной терапии инфекционно-воспалительных заболеваний, вызванных снижением показателей клеточного иммунитета, для профилактики инфекций, в процессе проведения лучевой и химиотерапии. Вводится внутримышечно по 50-100 мкг один раз в день, курсовая доза 300-1000 мкг, можно применять интраназально по 2-5 капель в каждую ноздрю 2-3 раза в день.
Тамерит – синтетическое производное фталгидразина – обладает противовоспалительным, иммуномодулирующим и антиоксидантным действием. Противовоспалительное действие обусловлено способностью препарата ингибировать избыточную продукцию макрофагами ФНО, ИЛ-1, нитросоединений активных форм кислорода на 10-12 часов.
Иммуномодулирующие свойства проявляются в восстановлении нормальной антиген-презентирующей и секреторной функции клеток моноцитарно-макрофагальной системы, стимуляции микробицидной системы нейтрофильных гранулоцитов и цитотоксической активности естественных киллеров.
Антиоксидантное действие реализуется за счет уменьшения потребления кислорода гиперактивированными макрофагами с последующим снижением генерации свободных радикалов.
Тамерит стимулирует репарацию тканей, активирует рост грануляций, ускоряет заживление инфицированных ран [44]. Применяется при воспалительных заболеваниях, септических состояниях, послеоперационных осложнениях. При вторичной иммунной недостаточности, вызванной химиотерапией, Тамерит вводят по 100 мг один раз в день два дня подряд, далее 100 мг один раз в три дня курсом до 15-20 инъекций.
Имунофан – гексапептид, в организме разрушается до естественных аминокислот: аргинина, тирозина, валила, лизила. Обладает иммунорегулирующим, детоксикационным, гепатопротективным и антиоксидантным действиями.
Действие препарата проходит несколько фаз и продолжается 4 месяца. В течение быстрой фазы, начинающейся через 2-3 часа после введения и длящейся 2-3 суток, вследствие стимуляции продукции церуллоплазмина и лактоферрина усиливается антиоксидантная защита, нормализуется перекисное окисление липидов, ингибируется распад фосфолипидов клеточных мембран. В течение средней фазы, 2-3 – 7-10 суток, происходит усиление фагоцитоза. Во время этой фазы происходит гибель внутриклеточных бактерий и вирусов, и воспаление несколько усиливается за счет персистенции вирусных и бактериальных антигенов. В медленную фазу, от 7-10 дней до 4 месяцев, проявляется иммуномодулирующее действие – нарушение восстановление показателей клеточного и гуморального иммунитета путем восстановления иммунорегуляторного индекса, активирования пролиферации и дифференцировки Т-клеток за счет усиления продукции ИЛ-2, увеличения продукции специфических антител [45].
Имунофан применяют для профилактики и лечения иммунодефицитных состояний различной этиологии. При токсическом и инфекционном поражении печени препарат предотвращает цитолиз, снижает активность трансаминаз и уровень билирубина в сыворотке крови. В онкологии Имунофан используется: перед операцией 1 мл 0,005% раствора 2-3 инъекции подкожно или внутримышечно; перед химио- или лучевой терапией 3-5 введений через день; в стадии генерализации опухоли 5-7 раз через день каждые три недели трижды [46].
5-тикратное использование Имунофана по 2 мл через день на фоне химиотерапии у 375 больных не только улучшило переносимость последней – на 17% реже возникала лейкопения и в 1,5-2 раза проявления гепатотоксичности; но и у 80% по сравнению с 63% в контроле отмечено быстрое восстановление лейкоцитов, достоверно увеличился процент эффективности химиотерапии на 7 [76].
Неовир – оригинальный отечественный препарат, при введении вызывает быстрое образование в организме интерферонов, идентифицированных как ранний альфа- и бета-интерфероны. Этот препарат индуцирует реакции, направленные на уничтожение вируса, а также готовит иммунокомпетентные клетки к повышенному выбросу интерферона в ответ на последующее воздействие болезнетворного агента. По динамике сывороточного титра интерферона доза Неовира 250 мг эквивалентна 6-9 млн. МЕ реаферона.
Иммуностимулирующее действие обусловлено активацией стволовых клеток костного мозга, Т-лимфоцитов и макрофагов системы полиморфно-ядерных лейкоцитов, нормализацией баланса между субпопуляциями Т-хелперов и Т-супрессоров.
Эффективен при некоторых РНК- и ДНК-геномных вирусах (вирусы группы Herpes, гриппа), инфицировании хламидиями, кандидозе слизистых. При ВИЧ и герпесе снижает продукцию ФНО, повышает способность лейкоцитов к синтезу альфа-интерферона, стимулирует образование активных форм кислорода.
Отмечена способность препарата купировать вторичную резистентность к тамоксифену при гормонозависимом раке молочной железы, что обусловлено увеличением экспрессии рецепторов прогестина и эстрогена и элиминацией рецептор-негативного пула.
При опухолевых заболеваниях считается, что Неовир усиливает активность естественных киллеров и нормализует продукцию ФНО, что должно сказываться на качестве жизни, предотвращая кахексию. Но это показание применения не нашло из-за проявлений токсичности (гриппоподобный синдром, болезненность в месте инъекции) и высокой стоимости препарата. Для терапии кахексии также малоприемлема инъекционная форма введения лекарственного средства.
Попытки терапии чувствительных к интерферонам злокачественных опухолей также дали неубедительные результаты. Дело в том, что при использовании индукторов интерферона рано или поздно клетка вступает в фазу гипореактивности, когда повторное введение препарата не вызывает ответной продукции интерферона, либо она настолько низка, что не вызывает какого-либо значимого ответа. Неовир может включаться в качестве дополнительного средства в комплексную терапию распространенных почечно-клеточного рака или меланомы. Вводится внутримышечно по 250 мг раз в день №5, терапия не из дешевых.
Низкомолекулярный индуктор альфа- вета- и гамма-интерферона Амиксин стимулирует его образование клетками эпителия кишечника, гепатоцитами, Т-лимфоцитами и гранулоцитами; стимулирует стволовые клетки костного мозга, увеличивает продукцию Ig M, Ig A и Ig G, восстанавливает соотношение Т-хелперов и Т-супрессоров.
Амиксин использовался в комплексном лечении больных с железисто-кистозной гиперплазией эндометрия. Исходное снижение продукции всех интерферонов отмечено у 80%, угнетение функциональной активности Т-лимфоцитов со снижением соотношения Т-хелперы и Т-супрессоры. После амиксина только у 20% осталась сниженной продукция интерферонов, Т-лимфоциты нормализовались у всех больных [74]. При приеме препарата до начала гормональной терапии отмечался более быстрый и полный клинико-морфологический эффект.
В результате индукции эндогенного интерферона оказывает антипролиферативное действие на опухолевые клетки.
Активен против гепато-, герпес- и миксовирусов [115]. Широко используется для профилактики гриппа и ОРВИ. В первые два дня внутрь принимается 1-2 таблетки после еды, следующие приемы – через 48 часов по 1 таблетке. Продолжительность курса от 1 до 4 недель зависит от нозологической формы.
Синтетический пептид Гепон также является индуктором альфа- и бета-интерферона, активирует макрофаги, ограничивает выработку ИЛ-1, ИЛ-6, ИЛ-8, ответственных за воспаление, и ФНО. Препарат привлекает моноциты в зону воспаления, усиливает синтез антител против антигенов инфекционной природы. У больных с ослабленным иммунитетом Гепон частично или полностью восстанавливает количество иммунокомпетентных клеток в истощенных популяциях лейкоцитов и лимфоцитов, повышает функции отдельных звеньев иммунитета [139].
Эффективен при ВИЧ и герпесе, так как подавляет репликацию вируса непосредственно в инфицированных клетках и одновременно активирует иммунные реакции [47]. При курсовом применении предупреждает рецидивы оппортунистических инфекций в течение 3-6 месяцев. Местное орошение Гепоном подавляет рост Candida, так как препарат хорошо всасывается и активирует местный иммунитет [139]. Выпускается в виде порошка для растворения и приема внутрь или орошения слизистых.
В отличие от других иммуномодуляторов, обладает широким спектром токсических реакций у 25-30% больных: диспепсия, энцефалитоподобный синдром, агранулоцитоз. Усиливает действие алкоголя (антабусподобный синдром) и непрямых антикоагулянтов. Запрещен при ревматоидном артрите с позитивным HLA-B 27.
Для стимуляции иммунитета Левамизол назначают по 150 мг 1 раз в сутки три дня подряд или по 150 мг 1 раз в неделю с обязательным контролем лейкоцитов. При раке ободочной кишки на 7 день после резекции по 50 мг 3 раза в день в течение трех дней каждые 2 недели на протяжении года.
Согласен Данный веб-сайт содержит информацию для специалистов в области медицины. В соответствии с действующим законодательством доступ к такой информации может быть предоставлен только медицинским и фармацевтическим работникам. Нажимая «Согласен», вы подтверждаете, что являетесь медицинским или фармацевтическим работником и берете на себя ответственность за последствия, вызванные возможным нарушением указанного ограничения. Информация на данном сайте не должна использоваться пациентами для самостоятельной диагностики и лечения и не может быть заменой очной консультации врача.
ВЛИЯНИЕ ИММУНОМОДУЛЯТОРОВ ИММУНОВАК ВП-4 И ПРОФЕТАЛЬ НА ФУНКЦИОНАЛЬНУЮ АКТИВНОСТЬ МОНОНУКЛЕАРНЫХ ЛЕЙКОЦИТОВ
Изучена иммуномодулирующая способность препаратов бактериального (вакцина Иммуновак-ВП-4) и эукариотического происхождения (профеталь), основным действующим компонентом которых является человеческий α-фетопротеин. Культивирование мононуклеарных лейкоцитов с иммуномодуляторами способствует увеличению количества клеток, экспрессирующих поверхностные антигены цитотоксических лимфоцитов, натуральных киллеров и натуральных киллеров
T-клеток. Оба препарата обладают выраженным противоопухолевым действием in vitro: индуцируют активацию киллерных свойств мононуклеаров периферической крови человека, которые при этом приобретают свойственный им фенотип.
Ключевые слова
Об авторах
Список литературы
1. Ахматова Н.К. Изменение функциональной активности дендритных клеток, генерированных из клеток костного мозга мышей, под воздействием иммуномодулятора микробного происхождения//Цитокины и воспаление. -2007. -Т. 6, № 1. -С. 20-24.
2. Давыдов М.И., Нормантович В.А., Киселевский М.В., Волков С.М. Адоптивная иммунотерапия при опухолевых плевритах: клинико-лабораторное исследование//Российский онкологический журнал. -2000. -№ 6. -С. 14-17.
4. Черешнев В.А., Родионов С.Ю., Черкасов В.А., Малютина Н.Н., Орлов В.А. Альфа-фетопротеин.-Екатеринбург: УрО РАН, 2004. -C. 376.
5. Черешнев В.А., Лебединская О.В., Родионов С.Ю., Ахматова Н.К., Шубина И.Ж., Лебединская Е.А., Гаврилова Т.В., Киселевский М.В. Влияние препарата «Профеталь» на функциональную активность мононуклеарных лейкоцитов и дендритных клеток человека//Медицинская иммунология. -2005. -Т. 7, № 5-6. -С. 525-534.
6. Arase N., Arase H., Hirano S., Yokosuka T., Sakurai D., Satito T. IgE-mediated activation of NK cells through Fc gamma RIII//J. Immunol. -2003. -Vol. 15, N 6. -P. 3054-3058.
7. Bhardwaj N. Harnessing the immune system to treat cancer//J. Clin. Invest. -2007. -Vol. 117, (5). -P. 1130-1136.
8. Dudich E.I., Dudich E.I., Semenkova L.N., Dudich I.V. et al. Alpha-fetoprotein-induced apoptosis of cancer cells//Bull. Biol. Med. -2000. -Vol. 130, N 12. -P. 1127-1133.
9. Foss F.M. Immunologic mechanisms of antitumor activity//Semin. Oncol. -2002. -Vol. 29. -P. 5-11.
10. Galandrini R., Tassi I., Mattia G., Lenti L., Picolli M., Frati L., Santoni A. SH2-containing inositol phosphatase (SHIP-1) transiently translocates to raft domains and modulates CD16-mediated cytotoxicity in human NK cells//Blood. -2002. -Vol. 15, N 13. -P. 4581-4589.
11. Hook C., Telyatnikova N., Goodall J., Braud V., Carmichael A., Wills M. Effects of Chlamydia trachomatis infection on the expression of natural killer (NK) cell ligands and susceptibility to NK cell lysis//Clin. Exp. Immunol. -2004. -Vol. 138, N 1. -P. 54-60.
12. Ikeda H., Chamoto K., Tsuji T., Suzuki Y., Wakita D., Takeshima T., Nishimura T. The critical role of type-1 innate and acquired immunity in tumor immunotherapy//Cancer Sci. -2004. -Vol. 95, N 9. -P. 697-703.
13. Mullbacher A. Cell-mediated cytotoxicity in recovery from poxvirus infections//Rev. Med. Virol. -2003. -Vol. 13, N 4. -P. 223-232.
15. Narazona R., Casado J., Delarosa O., Torre-Cisneros J., Villanueva J., Sanchez B., Galiana M. Selective depletion of CD56(dim) NK cell subsets and maintenance of CD56(bright) NK cells in treatmentnaive HIV-1-seropositive individuals//J. Clin. Immunol. -2002. -Vol. 22, N 3. -P. 176-183.
16. Pillai A.B., George T.I., Dutt S., Teo P., Strober S. Host NKT Cells Can Prevent Graft-versus-Host Disease and Permit Graft Antitumor Activity after Bone Marrow Transplantation//J. Immunol. -2007. -Vol. 178 (10). -P. 6242-6251.
17. Taga K., Yamauchi A., Bloom E. Target cell-induced apoptosis in IL-2-activated human natural killer cells//Leuk. Lymphoma. -1999. -Vol. 32, N. 5. -P. 451-458.
18. Yamaguchi Y., Ohshita A., Kawabuchi Y., Ohta K., Shimizu K., Minami K., Hihara J. Adoptive immunotherapy of cancer using activated autologous lymphocytes-current status and new strategies//Hum. Cell. -2006. -Vol. 16, N 4. -P. 183-189.
19. Zund G., Ye Q., Hoerstrup S.P. Tissue engineering in cardiovascular surgery: MTT, a rapid and reliable quantitative method to assess the optimal human cell seeding on polymeric meshes//Eur. J. Cardiothorac. Surg. -1999. -Vol. 15, N 4. -P. 519-524.
Пролиферация мононуклеарных лейкоцитов. Влияние иммуномодуляторов на лейкоциты
Пролиферация мононуклеарных лейкоцитов. Влияние иммуномодуляторов на лейкоциты
В следующей серии экспериментов сравнивалось влияние иммуномодуляторов на спонтанную и стимулированную ФГА, пролиферативную активность МЛПК здоровых доноров.
Данные демонстрируют стимулирующий эффект иммуномодуляторов на пролиферативный потенциал МЛПК. При использовании АСО процент властных форм нарастает от 18,4 до 42,0 и максимальный индекс стимуляции при этом составляет 10,0. Стимулирование ФГА обусловило увеличение этих показателей (34,8 и 61,3), соответственно. Индекс стимуляции составил при большей дозе 14,6. Во всех случаях показатели без ФГА и с ФГА существенно отличаются.
Эта же закономерность прослеживается при введении в среду Иммуновак-ВП-4 и ГМДП. Выявлено четкое возрастание индекса стимуляции при увеличении концентрации ИММП и добавлении ФГА. Сравнение средних концентраций иммуномодуляторов показывает, что собственное влияние Иммуновак-ВП-4 (1 мкг/мл) на пролиферативную активность выше влияния АСО (0,15 ЕС/мл) в 1,9 раза, а ГМДП (1 мкг/мл) в 1,4 раза.
Результаты этого исследования были подтверждены в следующем эксперименте при использовании другого методического подхода — теста восстановления витального красителя Alamar Blue (Biosours, USA). Проведенные эксперименты показали, что, как и в предыдущем случае, активность ВП-4 и ГМДП была выше по сравнению с АСО и контрольными группами.
Цитотоксический эффект NK воспроизводится in vitro, и это свойство лимфоцитов используют для оценки их киллерной активности. В отличие от цитотоксических специфических лимфоцитов естественные киллеры распознают свои мишени без участия главного комплекса гистосовместимости I и II классов.
Одним из методов оценки противоопухолевой активности иммуномодулирующих препаратов является определение спонтанной и стимулированной митогенами цитотоксичности мононуклеарных лейкоцитов периферической крови (МЛПК) in vitro. С этой целью применяют митогены растительного (пектины) и бактериального происхождения (ЛПС), являющиеся наиболее сильными неспецифическими активаторами клеток иммунной системы.
Их использование в качестве референс-препаратов дает возможность оценить степень влияния различных ИММП на активность МЛПК по способности разрушать опухолевые клетки-мишени in vitro.
В настоящем исследовании стимулирующий эффект бактериальной вакцины ВП-4 на цитотоксическую активность МЛПК сравнивали с действием неспецифических поликлональных активаторов: Т-клеточного митогена — ФГА и В-клеточных митогенов — ЛПС К. pneumoniae и E. coli. В предварительных исследованиях было установлено отсутствие прямого цитотоксического действия препаратов на опухолевые клетки в диапазоне воздействующих концентраций от 0,1 до 10,0 мкг/мл.
Для изучения модулирующей активности митогенов и вакцины на цитотоксический эффект МЛПК по отношению к клеткам рака толстой кишки человека Colo использовали различные соотношения МЛПК и опухолевых клеток, а также доз препаратов. Уменьшение соотношения опухолевые клетки/МЛПКс 1:5 до 1:2,5 и 1:1 приводило к снижению спонтанной цитотоксичности в отношении опухолевых клеток (с 38,0±1,0% до 32,6±0,9% и 20,9±0,3% соответственно).
Значения цитотоксической активности мононуклеаров в присутствии ФГА, ЛПС и ВП-4 в среде культивирования достигали максимальных значений при соотношении клеток 1:5 и концентрации препаратов 10 мкг/мл.
Информация на сайте подлежит консультации лечащим врачом и не заменяет очной консультации с ним.
См. подробнее в пользовательском соглашении.
Пролиферация мононуклеарных лейкоцитов. Влияние иммуномодуляторов на лейкоциты
В настоящее время для терапии онкологических и инфекционных заболеваний создаются бактериальные иммуномодулирующие препараты, активирующие макрофаги, лимфоциты, натуральные киллеры (НK-клетки), супрессированные опухолевым процессом.
Цель работы - исследование влияния бактериальной вакцины на цитотоксическую активность (ЦА) мононуклеарных лейкоцитов (МЛ) периферической крови человека в культурах.
МЛ выделяли из стабилизированной гепарином периферической крови 15 здоровых доноров. Кровь, разведённую в 2 раза средой 199, центрифугировали в градиенте плотности фиколл-урографина. МЛ, образовавшие интерфазное кольцо, собирали, отмывали в среде 199 и осаждали центрифугированием. Для дальнейшего использования в эксперименте культивировали клетки-мишени эритробластного лейкоза К-562 и колоректального рака Соlo в среде RPMI-1640. Использовали поликомпонентную вакцину «Иммуновак-ВП-4» из антигенов условно-патогенных микроорганизмов (ГУ НИИВС им. И.И. Мечникова РАМН), содержащую липополисаридный комплекс (ЛПС), ассоциированный с белком наружной мембраны грамотрицательных микроорганизмов, пептидогликан, тейхоевые кислоты и лабильные белковые компоненты стафилококка. Предварительно определяли прямое цитотоксическое действие вакцины на клетки линии К-562 и Соlo в концентрациях от 0,1 до 10,0 мкг/мл и установили отсутствие эффекта. В дальнейшем к МЛ добавляли вакцину в дозах от 0,01 до 10 мкг/мл и инкубировали в течение 72 часов. Для выявления ЦА клеток использовали тест восстановления 3-(4,5-диметилтиазол-2-ил)-2,5-дифенилтетразолия бромида (МТТ-тест). Цитотоксическую активность МЛ определяли на линии К-562 и Colo. Опухолевые клетки (3´104 в 1 мл) инкубировали в культуральной среде с обработанными вакциной МЛ в соотношениях 1:5; 1:2,5; 1:1 в микропланшетах. Затем в лунки добавляли витальный краситель МТТ и по оптической плотности, измеряемой на мультискане, рассчитывали процент лизиса опухолевых клеток. Максимальная спонтанная киллерная активность МЛ отмечалась при соотношении 1:5. При данном соотношении клеток-мишеней и клеток-эффекторов вакцина во всех дозах оказывала наибольший стимулирующий эффект на ЦА мононуклеаров по отношению к клеткам линии Соlo. Далее была изучена способность вакцины ВП-4 индуцировать НK-активность МЛ по отношению к клеткам линии К-562 с выбранным наиболее оптимальным соотношением клеток-мишеней и клеток-эффекторов - 1:5. Внесение в среду культивирования вакцины в концентрациях 1,0 и 10,0 мкг/мл достоверно повышало уровень цитотоксичности МЛ по отношению к клеткам линии К-562. В эксперименте наблюдался дозозависимый эффект влияния вакцины ВП-4 на цитотоксичность мононуклеарных лейкоцитов.
Можно предположить, что при использовании вакцины «Иммуновак-ВП-4» происходит: во-первых, взаимодействие антигенов препарата с ЛПС-рецепторами моноцитов/макрофагов, содержащихся в популяции МЛ с последующей инициацией секреции регуляторных цитокинов (IL-12, TNF и др.), а во-вторых, активация Т-лимфоцитов и НК-клеток (основных эффекторов противоопухолевого иммунитета) под действием белковых компонентов вакцины.
Сложные механизмы влияния подобных вакцин пока изучены недостаточно, что требует продолжения исследований для обоснования применения их в практике клинической онкологии в качестве иммуномодулирующих препаратов.
Пролиферация мононуклеарных лейкоцитов. Влияние иммуномодуляторов на лейкоциты
Дарья КУСЕВИЧ, врач-ревматолог, заместитель главного врача Клиники доктора Аникиной, руководитель направления «Ревматология»
Общий уровень лейкоцитов выше 9х109/л называется лейкоцитозом. Физиологический лейкоцитоз наблюдается при мышечной работе, эмоциональном напряжении, боли, приеме белковой пищи, резкой смене температуры окружающей среды, ионизирующей радиации. Указанные причины должны исключаться или, если это невозможно, учитываться при интерпретации результатов исследования.
Реактивный лейкоцитоз считается результатом усиления лейкопоэза в ответ на выброс провоспалительных факторов (цитокинов, токсинов, продуктов активации комплемента) и наблюдается при острых инфекциях и воспалениях, интоксикациях, обширных повреждениях тканей, опухолях, острых анемиях, постспленэктомическом состоянии. Лейкоцитоз чаще наблюдается при остро развивающейся инфекции и значительно реже – при хронических заболеваниях. Однако при этом повышение лейкоцитов в крови редко сопровождается пропорциональными изменениями числа нейтрофилов, лимфоцитов, моноцитов, эозинофилов или базофилов. И как раз по соотношению в крови клеток разного вида (лейкоцитарная формула) врач может сделать предварительное заключение о причине лейкоцитоза и об эффективности проводимой терапии. Cнижение общего количества лейкоцитов (менее 4 000 в 1 мкл) называется лейкопенией, причем чаще всего она обусловлена нейтропенией. В ее основе могут лежать наследственные и врожденные аномалии, а также приобретенные иммунодефициты. Лейкопения может быть следствием перенесенных активных вирусных процессов, например гриппа. У пациентов с аутоиммунными заболеваниями допустим постоянный дефицит лейкоцитов, однако не менее 3 000 в 1 мкл. Однако, независимо от причины изменения лейкоцитарной формулы, клинически лейкопения проявляется в снижении фагоцитарной активности и подавлении специфических иммунологических механизмов защиты. Это, в свою очередь, обусловливает частые бактериальные и вирусные инфекции.
Лейкоцитоз чаще наблюдается при остро развивающейся инфекции, реже – при хронических заболеваниях. Однако при этом повышение лейкоцитов редко сопровождается пропорциональными изменениями числа нейтрофилов, лимфоцитов, моноцитов, эозинофилов или базофилов
Гранулоциты
Нейтрофилы составляют 50–70% всех лейкоцитов. Нейтрофилез, то есть концентрация нейтрофилов, превышающая 6х109/л, может наблюдаться как при реактивном лейкоцитозе (когда увеличивается абсолютное и процентное содержание нейтрофилов), так и при физиологическом лейкоцитозе. Любое воспаление, бактериальные, грибковые и паразитарные инфекции (локализованные и генерализованные), некротические изменения тканей, интоксикации, гипоксемия и опухоли различной локализации будут сопровождаться увеличением числа нейтрофилов.
Однако при длительном воздействии факторов, индуцирующих нейтрофилез, происходит истощение костномозгового гранулоцитарного резерва, и в кровь выходят молодые клетки нейтрофильного ряда: палочкоядерные нейтрофилы, метамиелоциты, миелоциты и промиелоциты (происходит так называемый сдвиг лейкоцитарной формулы влево). Такое состояние крови носит название лейкемоидной реакции нейтрофильного типа и требует проведения дифференциальной диагностики с хроническим миелолейкозом. В этом случае необходимы дополнительные исследования, в первую очередь – уровня щелочной фосфатазы нейтрофилов крови. При реактивных состояниях он будет высоким, при хроническом миелолейкозе – низким. Кроме того, о миелолейкозе говорит выявление мРНК химерного гена ВСR/АВL, а в трепанобиоптате – гиперплазии кроветворной ткани.
Лейкоцитоз чаще наблюдается при остро развивающейся инфекции, реже – при хронических заболеваниях. Однако при этом повышение лейкоцитов редко сопровождается пропорциональными изменениями числа нейтрофилов, лимфоцитов, моноцитов, эозинофилов или базофилов
При числе нейтрофилов ниже 1,5х109/л диагностируют нейтропению, причиной которой могут быть аутоиммунные заболевания (системная красная волчанка, аутоиммунный тиреоидит), метаболические расстройства, в частности дефицит витамина В12, фолиевой кислоты, меди, действие радиации. Нейтропения может развиваться на фоне длительного белкового голодания, в первом триместре беременности, на фоне приема лекарственных препаратов. При ряде заболеваний абсолютное число нейтрофилов может быть резко сниженным, в то время как число лейкоцитов крови остается нормальным или даже повышенным за счет, например, лимфоцитов и бластных клеток.
Нейтропения характерна и для острых, и для хронических вирусных инфекций (Эпштейна–Барр, цитомегаловирус, ВИЧ, парвовирус В19). Она возникает при передозировке лекарственных препаратов (иммунодепрессантов), тяжелых поражениях печени.
Отдельно выделяется агранулоцитоз – резкое снижение нейтрофильных гранулоцитов менее 0,5х109/л на фоне ионизирующей радиации, отравления химическими веществами (бензолом), инсектицидами. Причиной агранулоцитоза могут быть приобретенная аплазия кроветворения при апластической анемии и миелофиброзе, прием некоторых лекарственных препаратов, вызывающих угнетение кроветворения (цитостатиков, вальпроевой кислоты, карбамазепина, бета‑лактамных антибиотиков) либо действующих как гаптены (антитиреоидные препараты).
Риск развития агранулоцитоза высок у больных ревматоидным артритом (синдром Фетти) и с почечной недостаточностью, а также у пациентов, получающих системную иммуносупрессивную терапию. В свою очередь снижение нейтрофилов приводит к повышенной восприимчивости к бактериальным и грибковым инфекциям.
Эозинофилы составляют очень небольшую долю лейкоцитов – 0,5–5%. И их концентрация выше 0,4х109/л называется эозинофилией. Она чаще всего служит признаком аллергизации организма при атопическом дерматите, поллинозе, аллергическом рините, бронхиальной астме, сывороточной болезни. Количество эозинофилов растет прямо пропорционально содержанию циркулирующих кортикостероидов. Дифференцировка эозинофилов из лейкоцитов происходит под влиянием колониестимулирующего фактора роста и интерлейкинов‑3 и -5, причем самым мощным стимулом является интерлейкин‑5, который, кроме того, увеличивает продолжительность жизни эозинофилов.
Соответственно, повышение уровня эозинофилов может происходить и при ревматологических заболеваниях, чаще всего при синдроме Чарджа‑Стросса. При этом также увеличивается СОЭ, СРБ и IgE. Диагностическим критерием является скопление эозинофилов во внесосудистом пространстве. В биоптате обнаруживают некротический васкулит мелких артерий и вен.
Стойкая и значительная эозинофилия может быть вызвана глистными инвазиями, поскольку именно эозинофилы ответственны за уничтожение паразитов
Стойкая и значительная эозинофилия может быть вызвана глистными инвазиями, поскольку именно эозинофилы ответственны за уничтожение паразитов. Злокачественные новообразования также сопровождаются ростом эозинофилов за счет продукции опухолью веществ, стимулирующих их выработку. Эозинофилия характерна и для первичных иммунодефицитов, а также для хронических форм туберкулеза. А вот при острых вирусных и бактериальных инфекциях наблюдается обратная картина – эозинопения, т. е. снижение уровня эозинофилов в крови. Поэтому при лихорадящем состоянии выявление повышенного числа эозинофилов требует поиска неинфекционной причины повышения температуры.
Эозинофилия, продолжающаяся более 6 месяцев при отсутствии этиологического фактора, расценивается как гиперэозинофильный синдром, характеризующийся также тяжелыми органными нарушениями, обусловленными токсическим действием эозинофилов. В случае обнаружения клонального характера кроветворения может быть диагностирован хронический эозинофильный лейкоз.
Агранулоциты
Моноциты составляют 2–10% от общего числа лейкоцитов. Если их уровень в крови превышает 0,8х109/л, это состояние называется моноцитозом. Реактивный моноцитоз может развиваться при персистенции возбудителя или любого другого антигена в организме, т. е. при хронических длительных инфекциях, аутоиммунных заболеваниях, реактивных гистиоцитозах и опухолях. Однако здесь тоже есть нюанс. Моноцитоз возникает и при острых и хронических моноцитарных и миеломоноцитарных лейкозах. Поэтому диагноз «хронический лейкоз» может быть поставлен только после тщательного обследования пациента и исключения всех возможных причин, способных вызвать реактивный моноцитоз. Для лейкоза характерна выраженная гиперплазия кроветворного костного мозга с почти полным вытеснением жировой ткани в трепанобиоптате костного мозга, при цитогенетическом исследовании выявляется клональный гемопоэз.
Лимфоциты составляют весьма значительную долю лейкоцитов – 19–37%. Увеличение их уровня более 3х109/л, или лимфоцитоз, в основном обусловлено вирусными и хроническими бактериальными инфекциями.
Для лейкоза характерна выраженная гиперплазия кроветворного костного мозга с почти полным вытеснением жировой ткани в трепанобиоптате костного мозга, при цитогенетическом исследовании выявляется клональный гемопоэз
Из вирусных заболеваний стоит отметить инфекционный мононуклеоз, который сопровождается выраженной бласттрансформацией лимфоцитов и появлением этих клеток в крови, а также реактивным лимфаденитом. Диагностика в этом случае основывается на сочетании ведущих клинических симптомов (лихорадка, ангина, увеличение лимфоузлов и селезенки) с характерной гематологической картиной (лимфоцитоз, более 10% атипичных мононуклеаров в двух анализах с интервалом более 5 дней). Оценивая результаты анализа, следует учитывать возраст пациента и динамику количества атипичных мононуклеаров – они нарастают к 10‑му дню болезни, а затем медленно, на протяжении нескольких месяцев, снижаются.
В пользу этого диагноза свидетельствует выявление антител класса IgM к капсидным антигенам при первичной инфекции и к ядерным – при уже имеющейся. Во всех случаях инфекционного мононуклеоза обязательно обследование и на ВИЧ‑инфекцию, так как при последней нередки случаи мононуклеозоподобного синдрома: увеличение лимфоузлов и количества мононуклеаров в крови.
Наличие атипичных мононуклеаров характерно не только для инфекционного мононуклеоза. Их количество возрастает при любых вирусных инфекциях, вакцинациях, при аутоиммунных заболеваниях, лекарственной непереносимости.
Некоторые онкогематологические заболевания – лейкоз из больших гранулярных лейкоцитов и хронический лимфоцитарный лейкоз – также будут вызывать рост числа лимфоцитов. Диагноз «лейкоз» ставится только в случаях, когда другие причины лимфоцитоза отвергнуты. В неясных случаях следует выполнять иммунофенотипирование или тест на клональность. Диагностическая ценность этих методов намного выше, нежели гистологического или цитологического исследований. При хроническом лимфоцитарном лейкозе или лимфоме выявляется моноклональный клеточный лейкоцитоз >5 000 в 1 мкл крови, тогда как для реактивных состояний характерна поликлональность лимфоцитов.
В клиническом анализе крови в обязательном порядке определяют объем эритроцитов и концентрацию гемоглобина. По этим важным показателям можно судить о многих патологических процессах в организме. Более подробно об этом мы расскажем в нашей следующей статье.
Читайте также:
